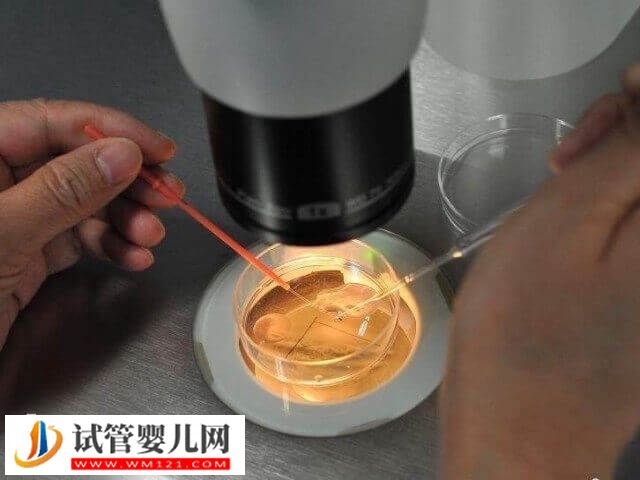
胚胎培養液對試管嬰兒有沒有影響(圖1)

胚胎培養液對試管嬰兒有沒有影響
胚胎培養液對試管寶寶是沒有任何的影響以及傷害的,培養液的主要成分包括水、鹽類、能量物質、氨基酸、維生素、蛋白質等,這些成分組成模擬胚胎在母體內發育的環境,其中的每一種成分都對胚胎的生長、發育起著重要的作用。總之,胚胎培養液是一種能夠促進胚胎發育的培養液,里面含有較多的營養物質,能夠滿足試管嬰兒的營養需求,一般不會對寶寶的生長發育造成影響。
胚胎培養液對試管是否有影響
胚胎培養液對試管寶寶不會有影響。首先,讓我們來了解一下形成胚胎的生命之液——培養液。培養液成份,它的基本構成是模擬正常女性體內的輸卵管液,里面含有大量的有利于胚胎發育的物質;每種成分都有自己重要的功能,都對胚胎的生長、發育起著重要的作用。一般來說,胚胎培養液主要包括:水、離子組成、能量底物、氨基酸、維生素、激素和生長因子、蛋白、抗生素等。
科學家對胚胎發育的環境條件和營養需求等做了大量的研究,包括培養液用水的質量、實驗室空氣的質量、各個階段胚胎對不同營養物質的需求量等。現在培養液和培養條件的改良能使50%左右的胚胎可以發育到囊胚階段。這樣,試管嬰兒實驗室的技術人員就能夠選擇質量更好的、發育更進一步的胚胎(囊胚)用來移植,而且只移植1或2枚胚胎。這樣一來,不但提高了懷孕率,而且也減少了多胎妊娠的可能。





